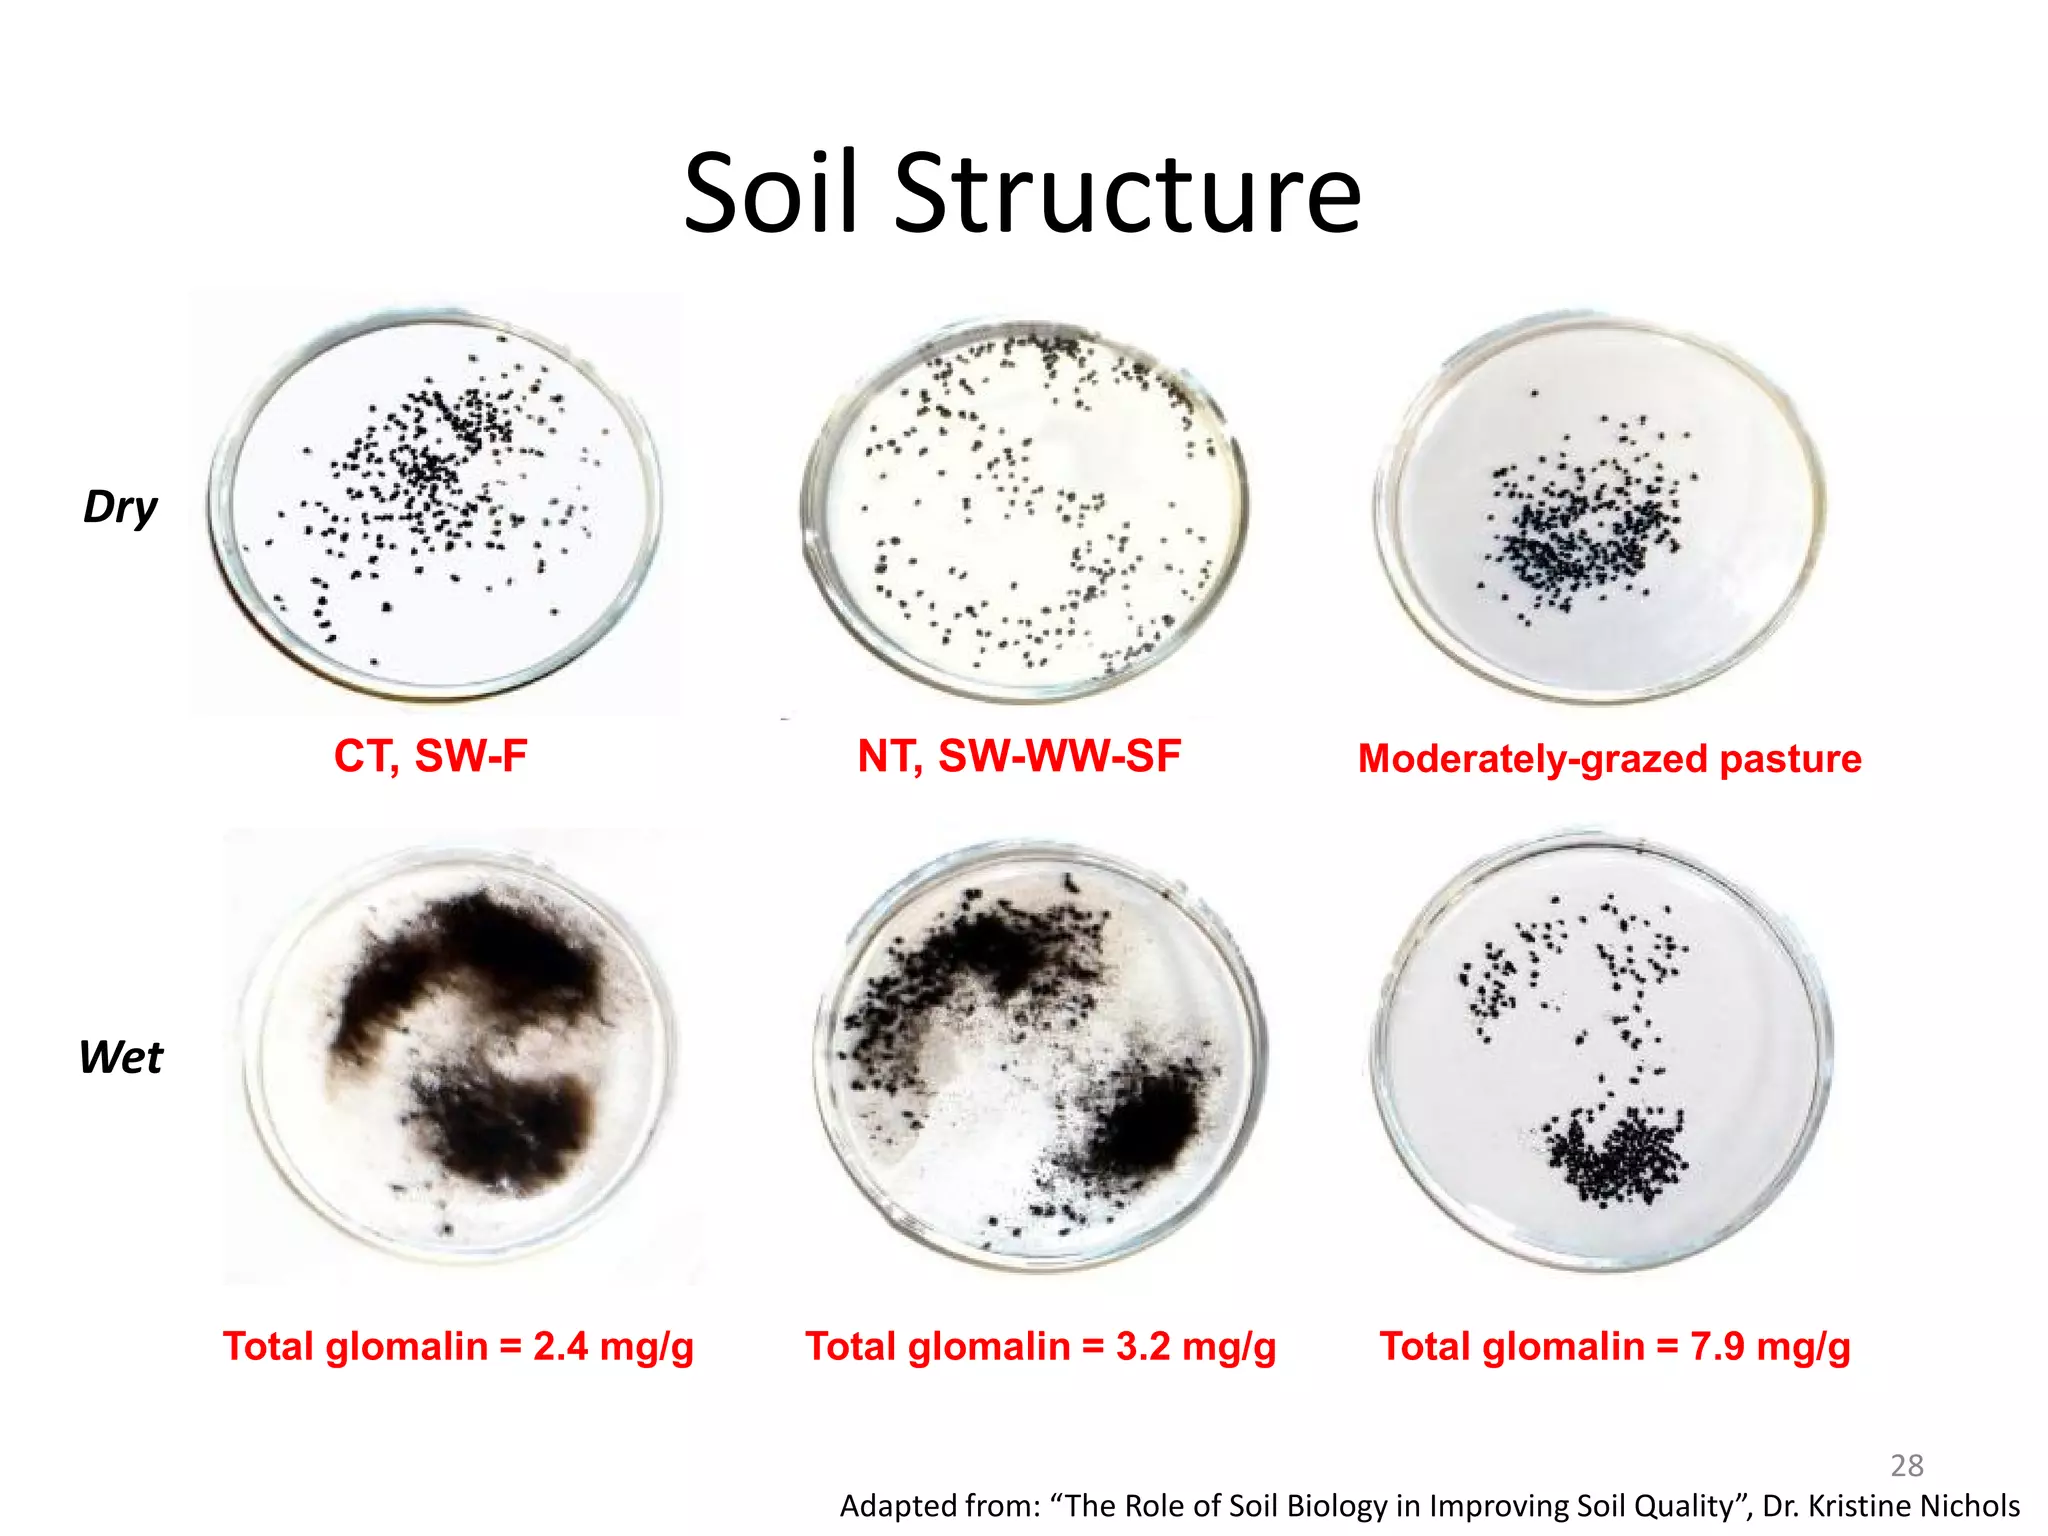
CT, SW-F NT, SW-WW-SF Moderately-grazed pasture
WSA = 14%
Total glomalin = 2.4 mg/g
WSA = 47%
Total glomalin = 3.2 mg/g
WSA = 93%
Total glomalin = 7.9 mg/g
Soil Structure
Adapted from: “The Role of Soil Biology in Improving Soil Quality”, Dr. Kristine Nichols
Dry
Wet
28

This document discusses soil organisms and their importance for soil health. It describes the different types of soil life from micro to macro organisms. Soil is teeming with life, with a single teaspoon containing billions of bacteria and thousands of pounds of fungi per acre. Soil organisms perform vital functions like nutrient cycling, maintaining soil structure, symbiotic nutrient exchange, and disease suppression. Management practices like no-till, complex crop rotations, cover crops, and organic amendments can improve soil life and its functions. Maintaining diverse, abundant soil life is key to increasing soil and crop productivity over the long term.